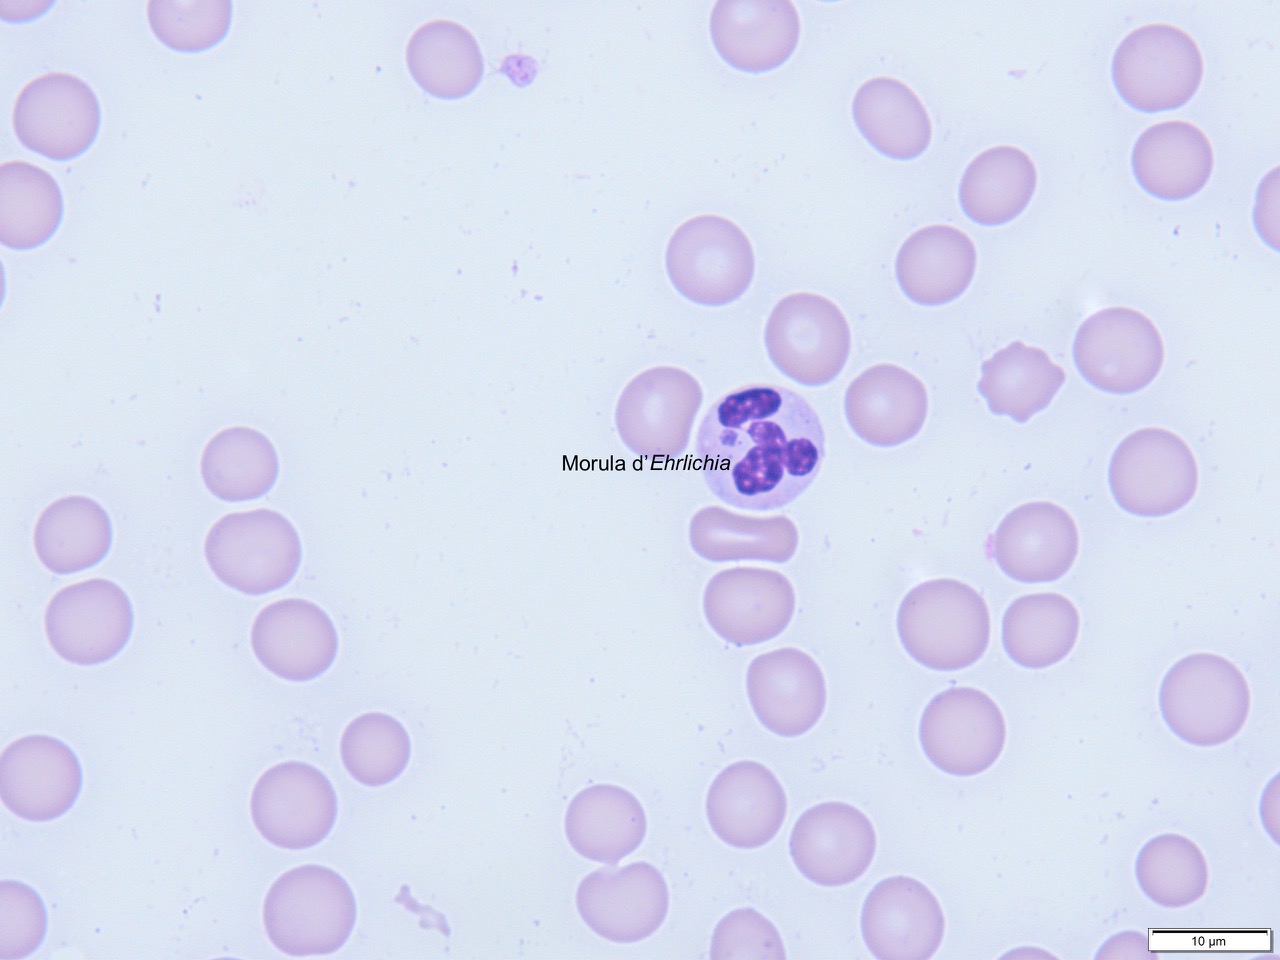
Formation MED006-L : Difficultés en infectiologie des animaux de compagnie: abord par cas cliniques. Formation MED006-L : Difficultés en infectiologie des animaux de compagnie: abord par cas cliniques.

Tarifs & Dates de la formation
DATE
ADRESSE & HORAIRES
INSCRIP.
04/11
Durée : 5 sessions de 1.5h en classe numérique de 13:00 à 14:30
Date limite d'inscription : 6 Octobre
Classe numérique : 07/10/26, 14/10/26, 21/10/26, 28/10/26, 04/11/26
Modalités de la formation
Type : Classe Numérique
Nombre de participants : maximum 12
Durée : 5 sessions de 1.5h en classe numérique de 13:00 à 14:30
Objectifs d'enseignement
CETTE FORMATION EST-ELLE POUR MOI ?
Je veux savoir rechercher, comprendre et interpréter les maladies infectieuses des carnivores domestiques, afin d'organiser une prise en charge et un suivi efficaces de mes patients.Pré-requis
Être vétérinaire diplômé (Docteur Vétérinaire)Objectifs pédagogiques
À l'issue de la formation, le participant sera capable pour les maladies infectieuses abordées (leptospirose, PIF, pneumonies bactériennes, rétroviroses félines, parvovirose et typhus), de :- Citer :
• Les indices clés pour suspecter chaque maladie infectieuse.
• Les mesures de protection adaptées pour les congénères, les propriétaires et l'équipe soignante.
• Les avantages et limites des tests rapides disponibles.
- Choisir l'outil d'évaluation le plus adapté selon la situation :
• Recherche directe (microscopie, test antigénique, culture, PCR).
• Recherche indirecte (sérologie rapide ou en laboratoire).
• Et justifier ce choix.
- Organiser et gérer le suivi clinique et biologique des patients.
- Communiquer avec certitude et adapter son discours face aux propriétaires.
- Expliquer clairement les enjeux, le pronostic et les conduites à tenir lors de PIF, de parvovirose et de typhus.
Déroulement de la formation
5 sessions de 1h30 centrées sur des cas concrets pour relier théorie, diagnostic et pratique clinique.
Session 1 – Pneumonies bactériennes
Confirmer, comprendre et suivre.
• Identifier les indices évocateurs d'une pneumonie infectieuse.
• Déterminer les facteurs prédisposants.
• Mettre en place une prise en charge adaptée et un suivi structuré.
Session 2 – Leptospirose
Du soupçon au pronostic.
• Reconnaître les signes évocateurs et les situations à risque.
• Indiquer et interpréter les tests de recherche.
• Quelle prise en charge et quel pronostic ?
Session 3 – Rétroviroses félines (FeLV / FIV)
Tester, comprendre, conseiller.
• Mesurer l'impact sur l'immunité et les risques infectieux associés.
• Déterminer la conduite à tenir face à un résultat positif.
• Évaluer les risques néoplasiques et mettre en place des mesures prophylactiques.
Session 4 – Péritonite infectieuse féline (PIF)
Entre suspicion et certitude.
• Savoir confirmer ou infirmer une suspicion clinique.
• Construire un discours clair, empathique et précis pour les propriétaires.
Session 5 – Parvovirose & Typhus
Tests, pronostic, communication.
• Identifier les tests de certitude et leurs limites.
• Évaluer les indicateurs pronostiques.
• Adopter la bonne attitude et le bon message face au propriétaire.
Session 1 – Pneumonies bactériennes
Confirmer, comprendre et suivre.
• Identifier les indices évocateurs d'une pneumonie infectieuse.
• Déterminer les facteurs prédisposants.
• Mettre en place une prise en charge adaptée et un suivi structuré.
Session 2 – Leptospirose
Du soupçon au pronostic.
• Reconnaître les signes évocateurs et les situations à risque.
• Indiquer et interpréter les tests de recherche.
• Quelle prise en charge et quel pronostic ?
Session 3 – Rétroviroses félines (FeLV / FIV)
Tester, comprendre, conseiller.
• Mesurer l'impact sur l'immunité et les risques infectieux associés.
• Déterminer la conduite à tenir face à un résultat positif.
• Évaluer les risques néoplasiques et mettre en place des mesures prophylactiques.
Session 4 – Péritonite infectieuse féline (PIF)
Entre suspicion et certitude.
• Savoir confirmer ou infirmer une suspicion clinique.
• Construire un discours clair, empathique et précis pour les propriétaires.
Session 5 – Parvovirose & Typhus
Tests, pronostic, communication.
• Identifier les tests de certitude et leurs limites.
• Évaluer les indicateurs pronostiques.
• Adopter la bonne attitude et le bon message face au propriétaire.
Documents de formations
Documents via Dropbox :
- Théorie en format .pdf
- Vidéos des cas cliniques utilisés pendant la formation.
- Théorie en format .pdf
- Vidéos des cas cliniques utilisés pendant la formation.
Méthodes mobilisées
Module de cinq sessions de 1h30 en format distanciel.
- Présentation théorique
- Etude de cas cliniques
- Contrôle des connaissances : QCM
- Présentation théorique
- Etude de cas cliniques
- Contrôle des connaissances : QCM
Attribution des points de formation (CFC)
Le suivi de l'intégralité de la formation et le succès au contrôle des acquis (au moins 10/20) créditent le participant de 1.5 CFC
Dernière mise à jour 11/12/2025